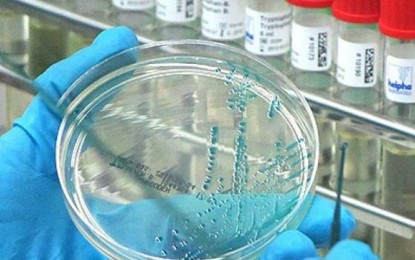
Bagong Strain ng Bird Flu (H5N9) sa Pilipinas: Paano ito nakakaapekto sa mga tao?

Bagong Strain ng Bird Flu (H5N9) sa Pilipinas: Paano ito nakakaapekto sa mga tao?
Marace Villahermosa • Ipinost noong 2025-05-07 16:19:17
Sa unang bahagi ng 2025, inanunsyo ng Pilipinas ang mga unang kaso ng H5N9 strain ng avian influenza, na nagresulta sa mabilis na pagkilos ng Department of Agriculture (DA) upang pigilan ang pagkalat nito. Bagaman ang H5N9 ay hindi kasing-nakamamatay ng ibang strain tulad ng H5N1, ito ay banta pa rin sa sektor ng manok at sa kalusugan ng publiko.
Ang DA ay nagsagawa ng ilang hakbang upang pigilan ang paglaganap. Kabilang dito ang pagpatay sa mga nahawaang ibon, pagtatatag ng mga quarantine zone, at pagpapalakas ng surveillance sa mga apektadong lugar. Pansamantala ring ipinagbawal ng gobyerno ang pag-angkat ng mga produkto ng manok mula sa mga bansang nakakaranas ng katulad na paglaganap upang maiwasan ang karagdagang pagpasok ng virus.
Para sa publiko, mababa pa rin ang posibilidad ng pagkahawa ng H5N9. Bihira ang impeksyon sa tao at karaniwang nakukuha sa direktang pagkalantad sa mga nahawaang ibon o kontaminadong kapaligiran. Gayunpaman, inirerekomenda ng mga awtoridad sa kalusugan ang pagpapanatili ng mabuting kalinisan, pag-iwas sa pakikipag-ugnayan sa mga may sakit o patay na ibon, at pagluluto ng mga produkto ng manok nang lubusan bago kainin.
Sa aspetong pang-ekonomiya, nagdulot ng pangamba ang krisis sa posibleng epekto sa suplay at presyo ng manok. Bilang pagsisikap na labanan ito, pinapabilis ng DA ang pag-angkat ng mga manok na nangingitlog at nag-aaplay para sa pag-apruba ng mga bakuna laban sa avian influenza para sa pagprotekta sa mga lokal na kawan. Ang mga hakbang na ito ay naglalayong patatagin ang industriya ng manok at mapanatili ang seguridad sa pagkain.
Ang paglaganap ng H5N9 avian flu strain sa Pilipinas ay banta sa kalusugan ng publiko at sa ekonomiya. Bagaman mababa pa rin ang posibilidad ng impeksyon sa tao, kailangan ang mas mataas na pag-iingat upang maiwasan ang posibleng pagkahawa. Ang mabilis na pagpigil ng gobyerno, gayundin ang pagsunod ng populasyon sa mga pamantayan sa kalusugan at kaligtasan sa pagkain, ay mahalaga sa pagkontrol sa pagkalat ng virus. Sa aspetong pang-ekonomiya, ang mga pre-emptive na hakbang tulad ng pagbabakuna sa manok, paghihigpit sa pag-angkat, at tulong sa industriya ay naglalayong bawasan ang epekto sa suplay at presyo ng pagkain. Sa huli, ang patuloy na koordinasyon sa pagitan ng mga awtoridad, magsasaka, at mamimili ay magiging kritikal sa pagpigil sa paglaganap at pagprotekta sa kalusugan ng publiko.
